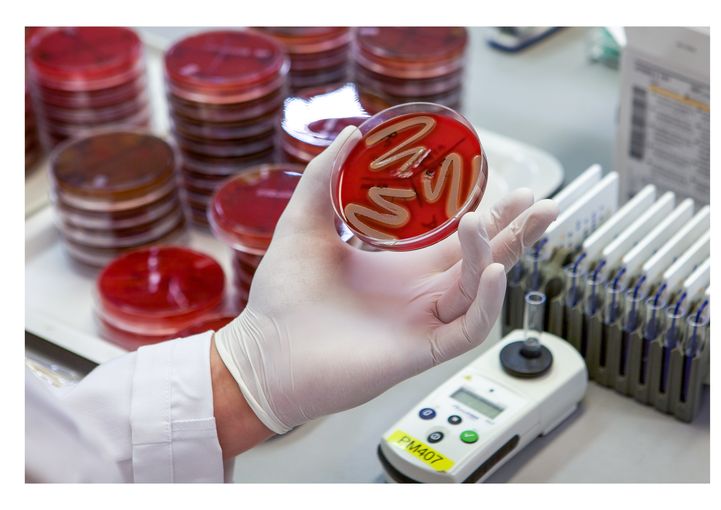
230531LaborRied014.jpg © OÖ TGD

TGD-Teilnehmerbeiträge sichern kostenfreie und kostengünstige Laboruntersuchungen und Leistungen
Bereits im Jahr 2025 mussten einnahmen- und ausgabenseitige Maßnahmen getroffen werden, um die mittel- und langfristige Finanzierung zu gewährleisten. Um bei einer rückläufigen öffentlichen Finanzierung die umfangreichen Leistungen weiter aufrecht erhalten zu können, wurde im Tiergesundheitsdienst der Beschluss gefasst, so wie in anderen Bundesländern auch, geringfügige nach Tierbestand gestaffelte Beiträge von den Teilnehmern (Tierhalter und Tierärzten) einzuheben. Der weitaus überwiegende Teil der anfallenden Kosten wird auch künftig durch das Land OÖ finanziert. Aus den Teilnehmerbeiträgen werden ca. 280.000 Euro an Einnahmen erwartet.
Die Mitteilung betreffend Einführung von TGD-Teilnehmerbeiträgen hat einige Fragen zum TGD hervorgerufen. Im Folgenden sollen daher einige allgemeine Informationen zu den Aufgaben und zur Finanzierung des Tiergesundheitsdienstes gegeben werden.
Neben den gesetzlichen Aufgaben werden vom Oö. TGD umfangreiche freiwillige Leistungen angeboten, die weiterhin zum allergrößten Teil aus öffentlichen Mitteln finanziert werden:
- Diagnostik zur Absicherung von Diagnosen (Sektion, Milch-, Blut-, Kot-, Harn- und Organuntersuchungen). Dazu betreibt der Oö. TGD ein eigenes Labor. Die bakteriologische Milchuntersuchung und die Erstellung von Antibiogrammen ist weiterhin kostenfrei. Auch das Screening zur Absicherung der BVD Freiheit wird weiterhin ohne Kosten für den Landwirt abgewickelt.
- Unterstützung beim Wissenstransfer (Vorträge, Weiterbildungsunterlagen, Filme, etc.).
- Beratung und Hilfestellung bei veterinären und tiergesundheitlichen Problemstellungen.
Was bringt die TGD-Teilnahme dem Tierhalter
- Beratung im Rahmen der Betriebserhebung durch den TGD Betreuungstierarzt
- Rechtssicherheit bei Anwendung von TGD-pflichtigen Arzneimitteln (Euterinjektoren, Injektabila)
- Günstigeren TGD Stundentarif, Entfall des Rechnungslegungszuschlags bei Arzneimitteln auf Basis einer Vereinbarung zwischen der Landwirtschaftskammer und Tierärztekammer
- Keine oder geringe Kosten bei Untersuchungen im Labor
- Hilfestellung bei Problemen in der Tiergesundheit
- Hilfestellung bei der Umsetzung gesetzlicher Vorgaben (Tierschutz, Tierseuchen, Tierarzneimittel, Zoonosen, etc.)
- Sicherheit im Tierverkehr (Freiheit von Krankheiten wie BVD, PRRS, Maedi/Visna, CAE)
- Teilnahme am TGD als Parameter in Qualitäts- und Vermarktungsprogrammen, um die Sicherheit der Lebensmittelproduktion in der Primärproduktion nachweisen zu können
- Grundlage für die Teilnahme an Qualitätsprogrammen. (AMA Gütesiegel, ÖPUL, Molkereien, etc.)
Warum braucht es einen TGD-Teilnehmerbeitrag
- Bereitstellung des notwendigen Eigenfinanzierungbetrages zur mittelfristigen Absicherung der größtenteils öffentlichen Finanzierung
- Bei Prüfungen wurde schon mehrmals kritisch angemerkt, dass seitens der Tierhalter und Tierärzte bisher keine Beiträge eingehoben werden
- Um die bisherigen Aufgaben und Leistungen (vor allem Laboruntersuchungen) weiter im vollen Umfang aufrechterhalten zu können
- Die Höhe der Beiträge ist nach Betriebsgröße abgestuft. 88 Prozent der Betriebe zahlen zwischen 25 und 35 Euro, 11 Prozent der Betriebe zahlen zwischen 45 und 55 Euro und 1 Prozent der Betriebe zahlen zwischen 65 und 75 Euro
- Tierärzte zahlen 1 Euro pro Betreuungsvertrag bzw. mindestens 25 Euro.
Tiergesundheitsdienst: effiziente und kostengünstige Aufgabenerledigung
Die steigenden Anforderungen im Rahmen von TGD Programmen und bundesländerübergreifenden Fragestellungen haben zur Gründung der Tiergesundheit Österreich geführt. Bundesländerübergreifende Aufgaben werden von der Tiergesundheit Österreich effizient erledigt (z.B. Antibiotikamonitoring im AHDS).
Im Zuge der TGD Novellierung im Jahr 2026 wird an einem neuen TGD Betreuungsmodell gearbeitet. Für TGD Betriebe, die nur geringe Leistungen in Anspruch nehmen wollen, werden sich das Betreuungsausmaß und damit auch die Kosten für Betriebsvisiten verringern.
Branchen bekennen sich zu TGD
- Die verantwortlichen Branchenvertreter und Mitgliedergruppen bekennen sich zu den Leistungen des OÖ TGD
- Beschlüsse zur Einführung von TGD-Teilnehmerbeiträgen wurden in den TGD-Gremien nach intensiver Diskussion von den verschiedenen Vertretern einstimmig gefasst.
Struktur und Aufgaben des OÖ TGD
9.816 TGD Betriebe und 327 TGD Tierärzte sind Teilnehmer des OÖ TGD.
Der OÖ TGD ist keine Behörde, sondern ein gemeinnütziger Verein, welcher gemäß der TGD-Verordnung anerkannt ist und die in der TGD-Verordnung festgelegten Aufgaben zu erfüllen hat.
- Durchführung von Laboruntersuchungen als Grundlage oder Absicherung für tierärztliche Diagnosen.
- Weiterbildungsmaßnahmen im Bereich Bestandesmanagement bei Nutztieren sowie Hilfestellungen bei tiergesundheitlichen Problemen.
- Umsetzung bundeseinheitlicher Vorgaben für TGD Programme: Registrierung und Verwaltung sowie Überwachung der Programmvorgaben.
- Zentrale Verrechnung der Betriebserhebungen: Jährlich sind etwa 12.000 Betriebserhebungen abzurechnen (Rechnung an den Tierhalter, Auszahlung an den Betreuungstierarzt).
- Registrierung und Verwaltung der Teilnehmer (Tierärzte und Tierhalter): Jährlich sind etwa 1.500 Vertragsänderungen (Kündigungen, Neubeitritte, Wechsel Bewirtschafter oder Tierarzt) zu verwalten.
- Durchführung der internen TGD Kontrollen: Gemäß den Bundesvorgaben müssen 1,5 Prozent der TGD Betriebe und 7 Prozent der TGD Tierärzte jährlich kontrolliert werden.
Das System Tiergesundheitsdienst, das im Jahr 2003 gegründet und eingerichtet wurde, hat sich im bestehenden Rechtsrahmen bestmöglich weiterentwickelt. Aufgrund der Änderungen der Strukturen und Anforderungen in der tierischen Produktion und struktureller Änderungen auf der Seite der Tierärzte bedarf es einer Anpassung und Ausrichtung auf die nächsten Jahre. Gutes soll beibehalten, Verbesserungspotentiale gesucht, Programme geprüft und gegebenenfalls adaptiert oder neukonzipiert werden. Eine aktuell anstehende Novellierung der TGD Verordnung muss dazu genutzt werden, dass der Tiergesundheitsdienst für Tierhalter und Betreuungstierärzte auch künftig den bestmöglichen Nutzen bringt.
Tiergesundheitsmanagement unverzichtbar
Ein aktives Tiergesundheitsmanagement ist in der modernen Nutztierhaltung aus Gründen des Tierwohls und der Wirtschaftlichkeit absolut unverzichtbar. Für die wirksame Umsetzung braucht es vor allem funktionierende Partnerschaften zwischen Tierärzten und Tierhaltern. Als Grundlage dafür ist die Erledigung der oben angeführten Aufgaben durch die Geschäftsstelle absolut unverzichtbar. Gleichzeitig arbeitet diese gemeinsam mit der Tiergesundheit Österreich an der Weiterentwicklung bestehender Tiergesundheitsprogramme, bei der regelmäßig auch unterschiedliche Interessen von Tierhalten und Tierärzten auf einen gemeinsamen Nenner gebracht werden müssen.